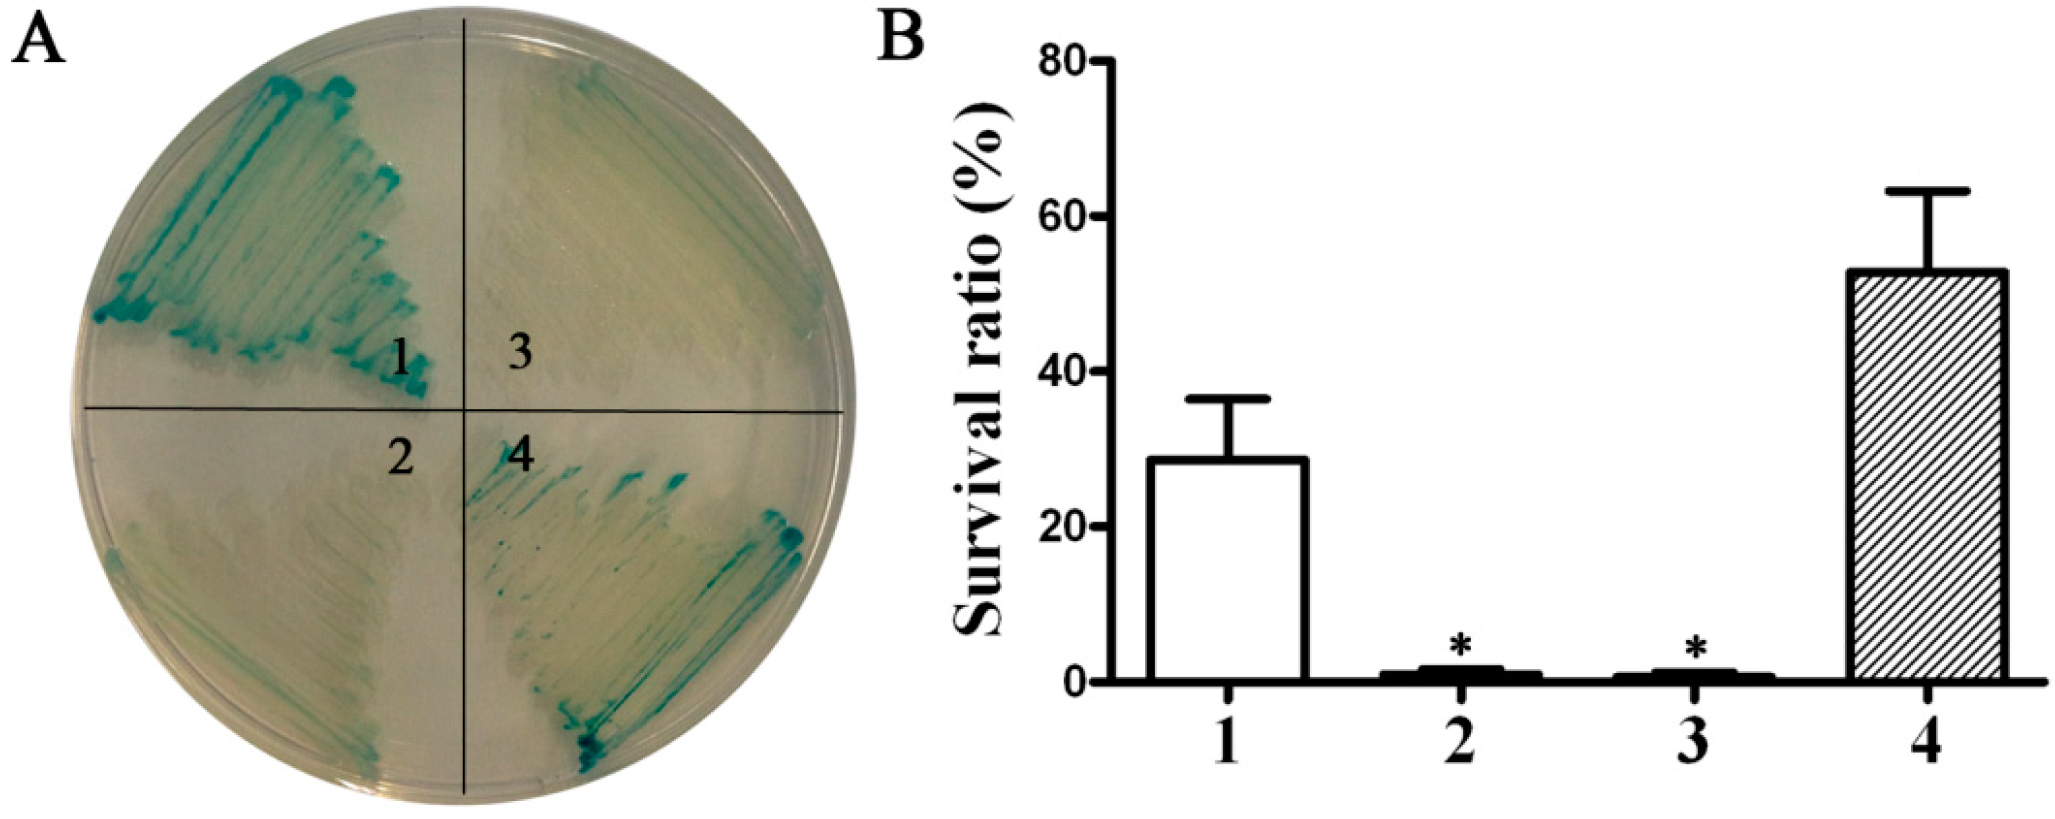
Ijms 17 00012 g001 1024

Identification of the Avian Pasteurella multocida phoP Gene and Evaluation of the Effects of phoP Deletion on Virulence and Immunogenicity
Abstract
:1. Introduction
2. Results and Discussion
2.1. Results
2.1.1. Cloning and Characterization of the phoP Gene of P. multocida

2.1.2. Construction of the Non-Polar ΔphoP Mutant in P. multocida 0818
2.1.3. Phenotype of the ΔphoP Mutant Strain

2.1.4. Virulence of Wild-Type P. multocida and the ΔphoP Mutant
| Route | Strains | Infection Dose (CFU) and Survival | LD50 | ||||||
|---|---|---|---|---|---|---|---|---|---|
| 103 | 104 | 105 | 106 | 107 | 108 | 109 | |||
| Intranasal | P. multocida 0818 | 5/5 | 7/8 | 8/16 | 1/16 | 0/16 | 0/8 | 0/8 | 8.66 × 104 |
| S413 (ΔphoP) | 8/8 | 8/8 | 7/8 | 12/16 | 9/16 | 5/16 | 0/8 | 1.33 × 107 | |
| Oral | P. multocida 0818 | – | 8/8 | 8/8 | 12/16 | 5/16 | 0/13 | 0/8 | 4.87 × 106 |
| S413 (ΔphoP) | – | 8/8 | 8/8 | 8/8 | 11/13 | 7/13 | 1/13 | 1.56 × 108 | |
2.1.5. Identification of Genes Regulated by phoP in P. multocida
| GeneID a | Locus | Description | Fold Change (log2) |
|---|---|---|---|
| Genes up-regulated in strain S413 (ΔphoP) | |||
| 1244903 | comF | competence protein ComF | 18.25 |
| 1243560 | PM0213 | membrane protein | 11.79 |
| 1244002 | cspA | cold-shock protein | 5.98 |
| 1244528 | lexA | repressor LexA | 5.73 |
| 1245238 | PM1891 | hypothetical protein | 5.39 |
| 1244663 | PM1316 | hypothetical protein | 4.66 |
| 1244906 | def | peptide deformylase, partial | 4.66 |
| 1244239 | impA | type VI secretion protein ImpA | 4.29 |
| 1244515 | rraA | ribonuclease activity regulator protein RraA | 4.06 |
| 1245264 | acpP | MULTISPECIES: acyl carrier protein | 4.00 |
| Genes down-regulated in strain S413 (ΔphoP) | |||
| 1244450 | aspA | aspartate ammonia-lyase | 9.92 |
| 1244459 | deaD | RNA helicase | 7.62 |
| 1244098 | PM0751 | DNA glycosylase | 7.16 |
| 1244150 | PM0803 | TonB-dependent receptor | 5.28 |
| 1243408 | rnc | ribonuclease III | 5.24 |
| 1243794 | resA | Pasteurella ResA protein | 5.03 |
| 1244644 | trmD | tRNA (guanine-N1)-methyltransferase | 4.96 |
| 1244642 | PM1295 | hypothetical protein | 4.66 |
| 1244511 | PM1164 | membrane protein | 4.66 |
| 1244107 | nusA | peptidase M54 | 4.53 |
| 1244535 | tonB | cell envelope protein TonB | 4.47 |
| 1244106 | infB | translation initiation factor IF-2 | 4.29 |
| 1244083 | dnaK | molecular chaperone DnaK | 4.14 |
| 1244389 | eptA | sulfatase | 4.11 |
2.1.6. Evaluation of the Immune Responses and Protection Rate Conferred by ΔphoP Mutant

| Group | Immunization | Challenge | Survival | Protection |
|---|---|---|---|---|
| Immune group | 105 CFU of S413 (ΔphoP) | 109 CFU of P. multocida 0818 | 6/11 | 54.5% |
| Control | PBS | 109 CFU of P. multocida 0818 | 0/8 | 0 |
2.2. Discussion
3. Experimental Section
3.1. Materials and Methods
3.1.1. Bacterial Strains, Plasmids, Media and Growth Conditions
| Strain or Plasmid | Description | Source |
|---|---|---|
| Strains | ||
| S184 | S. Typhimurium Δasd66 | Lab collection |
| S412 | S. Typhimurium Δasd66 ΔphoP85 | Lab collection |
| P. multocida 0818 | Wild type P. multocida serotype A strain. Capsulated and virulent | Lab collection |
| S413 | P. multocida 0818 ΔphoP::kanR | This work |
| χ7232 | E. coli K-12, endA1 hsdR17 (rK-, mK+) glnV44 thi-1 recA1 gyrA relA1 Δ(lacZYA-argF)U169 λpir deoR (φ80dlac Δ(lacZ)M15) | [39] |
| χ7213 | E. coli K-12, thi-1 thr-1 leuB6 glnV44 fhuA21 lacY1 recA1 RP4-2-Tc::Mu λpir ∆asdA4 ∆zhf-2::Tn10 | [39] |
| Plasmids | ||
| pQK664 | Asd+ Ptrc pSC101 origin replicationp15a, asd+, spec r | Derived from pYA3337 [36] |
| pQK167 | Insertion of phoP1 into pQK664 | This work |
| pQK168 | Insertion of phoP2 into pQK664 | This work |
| pYA4278 | pRE112 derivative, sacB mobRP4 R6K ori Cm+ | [38] |
| pQK171 | pYA4278-ΔphoP | This work |
| pQK173 | pYA4278-ΔphoP::kanR, for deletion of phoP in P. multocida | This work |
| pMC-Express | A broad host-range shuttle vector derived from pMIDG100, chloramphenicol r | [40] |
| pQK180 | Insertion of phoP into pMC-Express | This work |
3.1.2. Molecular and Genetic Procedures
| Primers | Sequence 5’-3’ |
|---|---|
| CphoP1-F | GCATGCCATGGAGGTACAAATGACCAAAAT |
| CphoP1-R | CGCGGATCCATACTTAATTGAAAAGGTTC |
| CphoP2-F | GCATGCCATGGCGGTCAAAAAAATGCGAAT |
| CphoP2-R | CGCGGATCCACGTGAAAATTAAACGAACC |
| CphoP-F | cgcGGATCCatgcgaattttattaatagaag |
| CphoP-R | ataagaatGCGGCCGCccgtaaacttgtttgcttaagc |
| DphoP-1F | TGCCAGTTTTCAATGGTGTC |
| DphoP-1R | CCTGCAGGGATGCGGCCGCTTTTTTGACCGCACTTTTTTC |
| DphoP-2F | GCGGCCGCATCCCTGCAGGGCTAGGAAAAAATGATGAAATG |
| DphoP-2R | ATTTTCCTTGATTGACTGGC |
| Kan-F | ATAAGAATGCGGCCGCTCAGTGGAACGAAAACTC |
| Kan-R | CCTGCAGGTTAGAAAAACTCATCGAGCATC |
| Primer 1 | TTAATTGGCAATGGCTTACAG |
| Primer 2 | TACCCTACACCATGCACAGT |
| Primer 3 | TATTACACACGTTATAACCCG |
| Primer 4 | CTGATTCAGGTGAAAATATTG |
| Primer 5 | CATTTGTGCAACTTCAGTTTG |
| Primer 6 | CAATATTTTCACCTGAATCAG |
| 16sRNA-F | TAATACCGCGTATTCTCTGAGG |
| 16sRNA-R | CCCTCCCTAAAGTACTCTAGAC |
3.1.3. Plasmid and Mutant Strain Construction
3.1.4. Phosphatase Activity and Polymyxin B Resistance Assays
3.1.5. Phenotype Determinations
3.1.6. Determination of LD50 in Ducks
3.1.7. Transcriptome Sequencing
3.1.8. Immunization and Challenge
3.1.9. Enzyme-Linked Immunosorbent Assay (ELISA)
3.1.10. Statistical Analyses
4. Conclusions
Supplementary Materials
Acknowledgments
Authors Contributions
Conflicts of Interest
References
- Harper, M.; Boyce, J.D.; Adler, B. Pasteurella multocida pathogenesis: 125 years after pasteur. FEMS Microbiol. Lett. 2006, 265, 1–10. [Google Scholar] [CrossRef] [PubMed]
- Chrzastek, K.; Kuczkowski, M.; Wieliczko, A.K.; Bednarek, K.J.; Wieliczko, A. Molecular epidemiologic investigation of polish avian pasteurella multocida strains isolated from fowl cholera outbreaks showing restricted geographical and host-specific distribution. Avian Dis. 2012, 56, 529–536. [Google Scholar] [CrossRef] [PubMed]
- San Millan, A.; Escudero, J.A.; Gutierrez, B.; Hidalgo, L.; Garcia, N.; Llagostera, M.; Dominguez, L.; Gonzalez-Zorn, B. Multiresistance in pasteurella multocida is mediated by coexistence of small plasmids. Antimicrob. Agents Chemother. 2009, 53, 3399–3404. [Google Scholar] [CrossRef] [PubMed]
- Ahmad, T.A.; Rammah, S.S.; Sheweita, S.A.; Haroun, M.; El-Sayed, L.H. Development of immunization trials against pasteurella multocida. Vaccine 2014, 32, 909–917. [Google Scholar] [CrossRef] [PubMed]
- Desin, T.S.; Koster, W.; Potter, A.A. Salmonella vaccines in poultry: Past, present and future. Expert Rev. Vaccines 2013, 12, 87–96. [Google Scholar] [CrossRef] [PubMed]
- Broset, E.; Martin, C.; Gonzalo-Asensio, J. Evolutionary landscape of the mycobacterium tuberculosis complex from the viewpoint of phopr: Implications for virulence regulation and application to vaccine development. MBio 2015. [Google Scholar] [CrossRef] [PubMed]
- Kier, L.D.; Weppelman, R.M.; Ames, B.N. Regulation of nonspecific acid phosphatase in salmonella: Phon and phop genes. J. Bacteriol. 1979, 138, 155–161. [Google Scholar] [PubMed]
- Gonzalo Asensio, J.; Maia, C.; Ferrer, N.L.; Barilone, N.; Laval, F.; Soto, C.Y.; Winter, N.; Daffe, M.; Gicquel, B.; Martin, C.; et al. The virulence-associated two-component PhoP-PhoR system controls the biosynthesis of polyketide-derived lipids in mycobacterium tuberculosis. J. Biol. Chem. 2006, 281, 1313–1316. [Google Scholar] [CrossRef] [PubMed]
- Perez, J.C.; Groisman, E.A. Transcription factor function and promoter architecture govern the evolution of bacterial regulons. Proc. Natl Acad. Sci. USA 2009, 106, 4319–4324. [Google Scholar] [CrossRef] [PubMed]
- Coornaert, A.; Chiaruttini, C.; Springer, M.; Guillier, M. Post-transcriptional control of the escherichia coli PhoQ-PhoP two-component system by multiple sRNAs involves a novel pairing region of GcvB. PLoS Genet. 2013, 9, e1003156. [Google Scholar] [CrossRef] [PubMed]
- Zwir, I.; Latifi, T.; Perez, J.C.; Huang, H.; Groisman, E.A. The promoter architectural landscape of the salmonella PhoP regulon. Mol. Microbiol. 2012, 84, 463–485. [Google Scholar] [CrossRef] [PubMed]
- Garcia Vescovi, E.; Soncini, F.C.; Groisman, E.A. Mg2+ as an extracellular signal: Environmental regulation of salmonella virulence. Cell 1996, 84, 165–174. [Google Scholar] [CrossRef]
- Prost, L.R.; Daley, M.E.; le Sage, V.; Bader, M.W.; le Moual, H.; Klevit, R.E.; Miller, S.I. Activation of the bacterial sensor kinase PhoQ by acidic pH. Mol. Cell 2007, 26, 165–174. [Google Scholar] [CrossRef] [PubMed]
- Bader, M.W.; Sanowar, S.; Daley, M.E.; Schneider, A.R.; Cho, U.; Xu, W.; Klevit, R.E.; le Moual, H.; Miller, S.I. Recognition of antimicrobial peptides by a bacterial sensor kinase. Cell 2005, 122, 461–472. [Google Scholar] [CrossRef] [PubMed]
- Lejona, S.; Aguirre, A.; Cabeza, M.L.; Garcia Vescovi, E.; Soncini, F.C. Molecular characterization of the Mg2+-responsive PhoP-PhoQ regulon in salmonella enterica. J. Bacteriol. 2003, 185, 6287–6294. [Google Scholar] [CrossRef] [PubMed]
- Dalebroux, Z.D.; Miller, S.I. Salmonellae phopq regulation of the outer membrane to resist innate immunity. Curr. Opin. Microbiol. 2014, 17, 106–113. [Google Scholar] [CrossRef] [PubMed]
- Lee, J.S.; Krause, R.; Schreiber, J.; Mollenkopf, H.J.; Kowall, J.; Stein, R.; Jeon, B.Y.; Kwak, J.Y.; Song, M.K.; Patron, J.P.; et al. Mutation in the transcriptional regulator PhoP contributes to avirulence of mycobacterium tuberculosis h37ra strain. Cell Host Microbe 2008, 3, 97–103. [Google Scholar] [CrossRef] [PubMed]
- Prost, L.R.; Miller, S.I. The salmonellae PhoQ sensor: Mechanisms of detection of phagosome signals. Cell. Microbiol. 2008, 10, 576–582. [Google Scholar] [CrossRef] [PubMed]
- Martin, C.; Williams, A.; Hernandez-Pando, R.; Cardona, P.J.; Gormley, E.; Bordat, Y.; Soto, C.Y.; Clark, S.O.; Hatch, G.J.; Aguilar, D.; et al. The live mycobacterium tuberculosis PhoP mutant strain is more attenuated than bcg and confers protective immunity against tuberculosis in mice and guinea pigs. Vaccine 2006, 24, 3408–3419. [Google Scholar] [CrossRef] [PubMed]
- Nambiar, J.K.; Pinto, R.; Aguilo, J.I.; Takatsu, K.; Martin, C.; Britton, W.J.; Triccas, J.A. Protective immunity afforded by attenuated, PhoP-deficient mycobacterium tuberculosis is associated with sustained generation of Cd4+ T-cell memory. Eur. J. Immunol. 2012, 42, 385–392. [Google Scholar] [CrossRef] [PubMed]
- Lee, H.Y.; Cho, S.A.; Lee, I.S.; Park, J.H.; Seok, S.H.; Baek, M.W.; Kim, D.J.; Lee, S.H.; Hur, S.J.; Ban, S.J.; et al. Evaluation of PhoP and Rpos mutants of salmonella enterica serovar typhi as attenuated typhoid vaccine candidates: Virulence and protective immune responses in intranasally immunized mice. FEMS Immunol. Med. Microbiol. 2007, 51, 310–318. [Google Scholar] [CrossRef] [PubMed]
- Wilson, B.A.; Ho, M. Pasteurella multocida: From zoonosis to cellular microbiology. Clin. Microbiol. Rev. 2013, 26, 631–655. [Google Scholar] [CrossRef] [PubMed]
- Galan, J.E.; Nakayama, K.; Curtiss, R., 3rd. Cloning and characterization of the asd gene of salmonella typhimurium: Use in stable maintenance of recombinant plasmids in Salmonella vaccine strains. Gene 1990, 94, 29–35. [Google Scholar] [CrossRef]
- Tacket, C.O.; Kelly, S.M.; Schodel, F.; Losonsky, G.; Nataro, J.P.; Edelman, R.; Levine, M.M.; Curtiss, R., 3rd. Safety and immunogenicity in humans of an attenuated Salmonella typhi vaccine vector strain expressing plasmid-encoded hepatitis B antigens stabilized by the asd-balanced lethal vector system. Infect. Immun. 1997, 65, 3381–3385. [Google Scholar] [PubMed]
- Steen, J.A.; Steen, J.A.; Harrison, P.; Seemann, T.; Wilkie, I.; Harper, M.; Adler, B.; Boyce, J.D. Fis is essential for capsule production in Pasteurella multocida and regulates expression of other important virulence factors. PLoS Pathog. 2010, 6, e1000750. [Google Scholar] [CrossRef] [PubMed]
- Paustian, M.L.; May, B.J.; Cao, D.; Boley, D.; Kapur, V. Transcriptional response of Pasteurella multocida to defined iron sources. J. Bacteriol. 2002, 184, 6714–6720. [Google Scholar] [CrossRef] [PubMed]
- Bosch, M.; Tarrago, R.; Garrido, M.E.; Campoy, S.; Fernandez de Henestrosa, A.R.; Perez de Rozas, A.M.; Badiola, I.; Barbe, J. Expression of the Pasteurella multocida ompH gene is negatively regulated by the Fur protein. FEMS Microbiol. Lett. 2001, 203, 35–40. [Google Scholar] [CrossRef] [PubMed]
- Uhlich, G.A.; McNamara, P.J.; Iandolo, J.J.; Mosier, D.A. Cloning and characterization of the gene encoding Pasteurella haemolytica fnrp, a regulator of the Escherichia coli silent Hemolysin shea. J. Bacteriol. 1999, 181, 3845–3848. [Google Scholar] [PubMed]
- Uhlich, G.A.; McNamara, P.J.; Iandolo, J.J.; Mosier, D.A. FnrP interactions with the Pasteurella haemolytica leukotoxin promoter. FEMS Microbiol. Lett. 2000, 186, 73–77. [Google Scholar] [CrossRef] [PubMed]
- Ryndak, M.; Wang, S.; Smith, I. Phop, a key player in mycobacterium tuberculosis virulence. Trends Microbiol. 2008, 16, 528–534. [Google Scholar] [CrossRef] [PubMed]
- Curtiss, R., 3rd; Wanda, S.Y.; Gunn, B.M.; Zhang, X.; Tinge, S.A.; Ananthnarayan, V.; Mo, H.; Wang, S.; Kong, W. Salmonella enterica serovar typhimurium strains with regulated delayed attenuation in vivo. Infect. Immun. 2009, 77, 1071–1082. [Google Scholar] [CrossRef] [PubMed]
- Garcia Vescovi, E.; Soncini, F.C.; Groisman, E.A. The role of the PhoP/PhoQ regulon in Salmonella virulence. Res. Microbiol. 1994, 145, 473–480. [Google Scholar] [CrossRef]
- Pisano, F.; Heine, W.; Rosenheinrich, M.; Schweer, J.; Nuss, A.M.; Dersch, P. Influence of PhoP and intra-species variations on virulence of yersinia pseudotuberculosis during the natural oral infection route. PLoS ONE 2014, 9, e103541. [Google Scholar] [CrossRef] [PubMed]
- Wilkie, I.W.; Grimes, S.E.; O’Boyle, D.; Frost, A.J. The virulence and protective efficacy for chickens of Pasteurella multocida administered by different routes. Vet. Microbiol. 2000, 72, 57–68. [Google Scholar] [CrossRef]
- Timmermans, J.; Van Melderen, L. Post-transcriptional global regulation by CsrA in bacteria. Cell. Mol. Life Sci. 2010, 67, 2897–2908. [Google Scholar] [CrossRef] [PubMed]
- Lautier, T.; Nasser, W. The DNA nucleoid-associated protein Fis co-ordinates the expression of the main virulence genes in the phytopathogenic bacterium Erwinia chrysanthemi. Mol. Microbiol. 2007, 66, 1474–1490. [Google Scholar] [CrossRef] [PubMed]
- Saldana, Z.; Xicohtencatl-Cortes, J.; Avelino, F.; Phillips, A.D.; Kaper, J.B.; Puente, J.L.; Giron, J.A. Synergistic role of curli and cellulose in cell adherence and biofilm formation of attaching and effacing Escherichia coli and identification of Fis as a negative regulator of curli. Environ. Microbiol. 2009, 11, 992–1006. [Google Scholar] [CrossRef] [PubMed]
- Kelly, A.; Goldberg, M.D.; Carroll, R.K.; Danino, V.; Hinton, J.C.; Dorman, C.J. A global role for Fis in the transcriptional control of metabolism and type III secretion in Salmonella enterica serovar typhimurium. Microbiology 2004, 150, 2037–2053. [Google Scholar] [CrossRef] [PubMed]
- Eraso, J.M.; Markillie, L.M.; Mitchell, H.D.; Taylor, R.C.; Orr, G.; Margolin, W. The highly conserved MraZ protein is a transcriptional regulator in Escherichia coli. J. Bacteriol. 2014, 196, 2053–2066. [Google Scholar] [CrossRef] [PubMed]
- Guina, T.; Yi, E.C.; Wang, H.; Hackett, M.; Miller, S.I. A PhoP-regulated outer membrane protease of Salmonella enterica serovar typhimurium promotes resistance to α-helical antimicrobial peptides. J. Bacteriol. 2000, 182, 4077–4086. [Google Scholar] [CrossRef] [PubMed]
- Hohmann, E.L.; Oletta, C.A.; Killeen, K.P.; Miller, S.I. PhoP/PhoQ-deleted Salmonella typhi (ty800) is a safe and immunogenic single-dose typhoid fever vaccine in volunteers. J. Infect. Dis. 1996, 173, 1408–1414. [Google Scholar] [CrossRef] [PubMed]
- Methner, U.; Barrow, P.A.; Berndt, A.; Rychlik, I. Salmonella enteritidis with double deletion in phopflic—A potential live salmonella vaccine candidate with novel characteristics for use in chickens. Vaccine 2011, 29, 3248–3253. [Google Scholar] [CrossRef] [PubMed]
- Aguilar, D.; Infante, E.; Martin, C.; Gormley, E.; Gicquel, B.; Hernandez Pando, R. Immunological responses and protective immunity against tuberculosis conferred by vaccination of Balb/C mice with the attenuated mycobacterium tuberculosis (Phop) so2 strain. Clin. Exp. Immunol. 2007, 147, 330–338. [Google Scholar] [CrossRef] [PubMed]
- Torres-Escobar, A.; Juarez-Rodriguez, M.D.; Curtiss, R., 3rd. Biogenesis of yersinia pestis psaa in recombinant attenuated Salmonella typhimurium vaccine (RASV) strain. FEMS Microbiol. Lett. 2010, 302, 106–113. [Google Scholar] [CrossRef] [PubMed]
- Cardenas, M.; Fernandez de Henestrosa, A.R.; Campoy, S.; Perez de Rozas, A.M.; Barbe, J.; Badiola, I.; Llagostera, M.; Molecular Microbiology, G. Virulence of Pasteurella multocidarecA mutants. Vet. Microbiol. 2001, 80, 53–61. [Google Scholar] [CrossRef]
- Kong, Q.; Yang, J.; Liu, Q.; Alamuri, P.; Roland, K.L.; Curtiss, R., 3rd. Effect of deletion of genes involved in lipopolysaccharide core and O-antigen synthesis on virulence and immunogenicity of Salmonella enterica serovar Typhimurium. Infect. Immun. 2011, 79, 4227–4239. [Google Scholar] [CrossRef] [PubMed]
- Roland, K.; Curtiss, R., 3rd; Sizemore, D. Construction and evaluation of a Δcya Δcrp salmonella Typhimurium strain expressing aviasn pathogenic Escherichia coli O78 LPS as a vaccine to prevent airsacculitis in chickens. Avian Dis. 1999, 43, 429–441. [Google Scholar] [CrossRef] [PubMed]
- Bosse, J.T.; Durham, A.L.; Rycroft, A.N.; Kroll, J.S.; Langford, P.R. New plasmid tools for genetic analysis of Actinobacillus pleuropneumoniae and other Pasteurellaceae. Appl. Environ. Microbiol. 2009, 75, 6124–6131. [Google Scholar] [CrossRef] [PubMed]
- Kawasaki, K.; China, K.; Nishijima, M. Release of the lipopolysaccharide deacylase PagL from latency compensates for a lack of lipopolysaccharide aminoarabinose modification-dependent resistance to the antimicrobial peptide polymyxin B in salmonella enterica. J. Bacteriol. 2007, 189, 4911–4919. [Google Scholar] [CrossRef] [PubMed]
- Hitchcock, P.J.; Brown, T.M. Morphological heterogeneity among salmonella lipopolysaccharide chemotypes in silver-stained polyacrylamide gels. J. Bacteriol. 1983, 154, 269–277. [Google Scholar] [PubMed]
- Fomsgaard, A.; Freudenberg, M.A.; Galanos, C. Modification of the silver staining technique to detect lipopolysaccharide in polyacrylamide gels. J. Clin. Microbiol. 1990, 28, 2627–2631. [Google Scholar] [PubMed]
- Roier, S.; Leitner, D.R.; Iwashkiw, J.; Schild-Prufert, K.; Feldman, M.F.; Krohne, G.; Reidl, J.; Schild, S. Intranasal immunization with nontypeable Haemophilus influenzae outer membrane vesicles induces cross-protective immunity in mice. PLoS ONE 2012, 7, e42664. [Google Scholar] [CrossRef] [PubMed]
- May, B.J.; Zhang, Q.; Li, L.L.; Paustian, M.L.; Whittam, T.S.; Kapur, V. Complete genomic sequence of Pasteurella multocida, Pm70. Proc. Natl Acad. Sci. USA 2001, 98, 3460–3465. [Google Scholar] [CrossRef] [PubMed]
- Langmead, B.; Salzberg, S.L. Fast gapped-read alignment with bowtie 2. Nat. Method 2012, 9, 357–359. [Google Scholar] [CrossRef] [PubMed]
- Li, B.; Dewey, C.N. Rsem: Accurate transcript quantification from RNA-Seq data with or without a reference genome. BMC Bioinform. 2011, 12, 323. [Google Scholar] [CrossRef] [PubMed]
- Robinson, M.D.; McCarthy, D.J.; Smyth, G.K. Edger: A bioconductor package for differential expression analysis of digital gene expression data. Bioinformatics 2010, 26, 139–140. [Google Scholar] [CrossRef] [PubMed]
© 2015 by the authors; licensee MDPI, Basel, Switzerland. This article is an open access article distributed under the terms and conditions of the Creative Commons by Attribution (CC-BY) license (http://creativecommons.org/licenses/by/4.0/).
Share and Cite
Xiao, K.; Liu, Q.; Liu, X.; Hu, Y.; Zhao, X.; Kong, Q. Identification of the Avian Pasteurella multocida phoP Gene and Evaluation of the Effects of phoP Deletion on Virulence and Immunogenicity. Int. J. Mol. Sci. 2016, 17, 12. https://doi.org/10.3390/ijms17010012
Xiao K, Liu Q, Liu X, Hu Y, Zhao X, Kong Q. Identification of the Avian Pasteurella multocida phoP Gene and Evaluation of the Effects of phoP Deletion on Virulence and Immunogenicity. International Journal of Molecular Sciences. 2016; 17(1):12. https://doi.org/10.3390/ijms17010012
Chicago/Turabian StyleXiao, Kangpeng, Qing Liu, Xueyan Liu, Yunlong Hu, Xinxin Zhao, and Qingke Kong. 2016. "Identification of the Avian Pasteurella multocida phoP Gene and Evaluation of the Effects of phoP Deletion on Virulence and Immunogenicity" International Journal of Molecular Sciences 17, no. 1: 12. https://doi.org/10.3390/ijms17010012
APA StyleXiao, K., Liu, Q., Liu, X., Hu, Y., Zhao, X., & Kong, Q. (2016). Identification of the Avian Pasteurella multocida phoP Gene and Evaluation of the Effects of phoP Deletion on Virulence and Immunogenicity. International Journal of Molecular Sciences, 17(1), 12. https://doi.org/10.3390/ijms17010012
